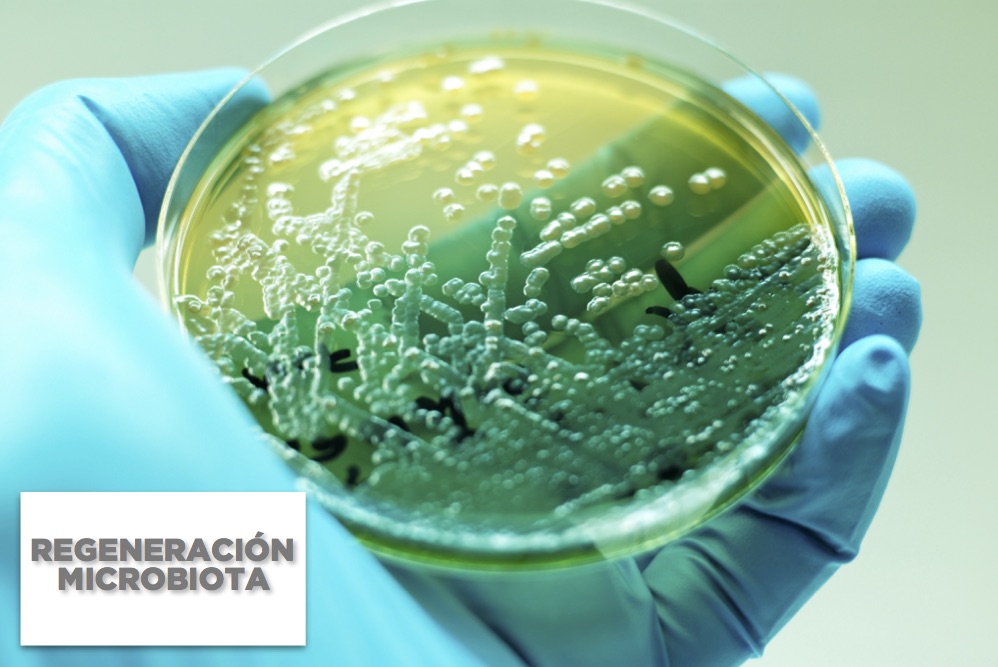
regeneracion microbiota portada 3

El papel del nutricionista es vital en la unidad de obesidad y sobrepeso ya que la alimentación y la salud, tal como planteaba la antigua medicina, están unidas por lazos muy estrechos. De hecho, es bien conocida la frase “somos lo que comemos” o aquella que dicta “que tu alimento sea tu medicina”. Desde tiempos antiguos, pasando a través de generaciones y llegando hasta nosotros, heredamos un tipo concreto de alimentación.